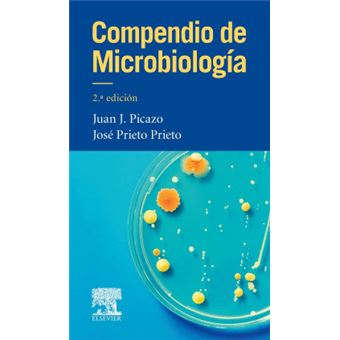
Compendio De Microbiología - 1

Compendio De Microbiología
J.J. Picazo De La Garza
Estado :
Novo
Vendido por
País de expedição : Brasil
Resumo
Ver tudo
Nueva edición de compendio de microbiología, dirigido por el profesorpicazo junto con el dr. prieto. ambos son catedráticos demicrobiología en la facultad de medicina de la ucm y desarrollan sulabor clínica en el servicio de microbiología clínica del hospitalclínico san carlos de madrid. asimismo, el profesor picazo es elactual presidente de la sociedad española de quimioterapia.
en la presente edición colabora un nutrido grupo de docentes, todosellos catedráticos de las siguientes plazas: ucm, santiago decompostela,...
en la presente edición colabora un nutrido grupo de docentes, todosellos catedráticos de las siguientes plazas: ucm, santiago decompostela,...

Compendio De Microbiología
Resumo
Nueva edición de compendio de microbiología, dirigido por el profesorpicazo junto con el dr. prieto. ambos son catedráticos demicrobiología en la facultad de medicina de la ucm y desarrollan sulabor clínica en el servicio de microbiología clínica del hospitalclínico san carlos de madrid. asimismo, el profesor picazo es elactual presidente de la sociedad española de quimioterapia.
en la presente edición colabora un nutrido grupo de docentes, todosellos catedráticos de las siguientes plazas: ucm, santiago decompostela, bilbao, valladolid, salamanca, badajoz, las palmas de gran canaria, córdoba, murcia, zaragoza y sevilla, con lo cual se trata de un texto representativo de la asignatura de microbiología para elgrado de medicina.
la nueva edición continua con la misma filosofía, es decir se trata de un compendio, un libro de formato bolsillo, muy manejable, asequibley que presente los conceptos fundamentales y esenciales que el alumnodebe saber.
el texto reúne los contenidos más relevantes de la microbiologíamédica, así como su implicación diagnóstica, epidemiológica yterapéutica. la obra se estructura en dos grandes apartados:microbiología general, donde el lector encontrará una detalladadescripción de los principales microorganismos causantes de patologíahumana, y microbiología clínica, donde se describen los grandessíndromes clínicos infecciosos.
esta nueva edición de compendio de microbiología presenta:
un formato más atractivo y manejable con contenidos totalmenteactualizados
la descripción de la mayoría de los microorganismos, además deenfoques diagnósticos y terapéuticos.
inclusión de un caso clínico al inicio de cada capítulo, parafavorecer la enseñanza basada en la resolución de problemas con el fin de acercar al alumno a la realidad de la práctica clínica.
al final de la obra se encuentran agrupadas las preguntas deautoevaluación e inmediatamente después las correspondientesrespuestas razonadas a cada una de ellas.
los directores de la obra quieren darle a la nueva edición un carácter aún más didáctico, y , por ello, van a incorporar: a) objetivosdocentes al inicio de capítulo, b) caso clínico simple e ilustrativoal inicio de capítulo, c) 4 o 5 preguntas cortas que pueden guardarrelación con el caso clínico (las respuestas aparecerán al final delcapítulo), d) desarrollo del tema (se incluirán más tablas, destacados en negrita...).
se tendrá en cuenta el cambio en cuanto a hábitos de estudio y decomportamiento del estudiante actual del grado de medicina, y seadaptarán los contenidos a la microbiología clínica moderna.
actualización con la incorporación de las novedades etiopatogénicas,diagnósticas y terapéuticas
en la presente edición colabora un nutrido grupo de docentes, todosellos catedráticos de las siguientes plazas: ucm, santiago decompostela, bilbao, valladolid, salamanca, badajoz, las palmas de gran canaria, córdoba, murcia, zaragoza y sevilla, con lo cual se trata de un texto representativo de la asignatura de microbiología para elgrado de medicina.
la nueva edición continua con la misma filosofía, es decir se trata de un compendio, un libro de formato bolsillo, muy manejable, asequibley que presente los conceptos fundamentales y esenciales que el alumnodebe saber.
el texto reúne los contenidos más relevantes de la microbiologíamédica, así como su implicación diagnóstica, epidemiológica yterapéutica. la obra se estructura en dos grandes apartados:microbiología general, donde el lector encontrará una detalladadescripción de los principales microorganismos causantes de patologíahumana, y microbiología clínica, donde se describen los grandessíndromes clínicos infecciosos.
esta nueva edición de compendio de microbiología presenta:
un formato más atractivo y manejable con contenidos totalmenteactualizados
la descripción de la mayoría de los microorganismos, además deenfoques diagnósticos y terapéuticos.
inclusión de un caso clínico al inicio de cada capítulo, parafavorecer la enseñanza basada en la resolución de problemas con el fin de acercar al alumno a la realidad de la práctica clínica.
al final de la obra se encuentran agrupadas las preguntas deautoevaluación e inmediatamente después las correspondientesrespuestas razonadas a cada una de ellas.
los directores de la obra quieren darle a la nueva edición un carácter aún más didáctico, y , por ello, van a incorporar: a) objetivosdocentes al inicio de capítulo, b) caso clínico simple e ilustrativoal inicio de capítulo, c) 4 o 5 preguntas cortas que pueden guardarrelación con el caso clínico (las respuestas aparecerán al final delcapítulo), d) desarrollo del tema (se incluirán más tablas, destacados en negrita...).
se tendrá en cuenta el cambio en cuanto a hábitos de estudio y decomportamiento del estudiante actual del grado de medicina, y seadaptarán los contenidos a la microbiología clínica moderna.
actualización con la incorporación de las novedades etiopatogénicas,diagnósticas y terapéuticas
Publicidade
Avaliações dos nossos clientes
Compendio De Microbiología
Sê o primeiro a dar
a tua opinião sobre este produto
Características
- Editora
-
Elsevier Editorial
- Idiomas
-
Espanhol
- EAN
-
9788490229217
Publicidade
Publicidade